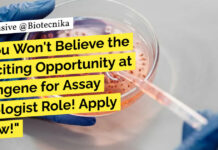
Syngene Vacancies Life Science

Home 2024
Yearly Archives: 2024
Application Specialist at Siemens Healthcare – MSc & PhD Biology, Biotech Apply Online
Application Specialist at Siemens Healthcare - MSc & PhD Biology, Biotech Apply Online
Application Specialist
Jaipur, Rajasthan, India
Job Description
Job ID: 437484
Company: Siemens Healthcare Private Limited
Organization: Siemens...
Pharmacovigilance Role at TCS Mumbai – Apply Now! BSc, MSc Life Sciences Eligible
Pharmacovigilance Role at TCS Mumbai - Apply Now! BSc, MSc Life Sciences Eligible
Pharmacovigilance
About the job
TCS is hiring for Pharmacovigilance.
Role: Pharmacovigilance
Work location: Mumbai
...
Scientist Protein Biology at ThermoFisher Scientific Inc! Apply Now
Scientist Protein Biology at ThermoFisher Scientific Inc! Apply Now
Scientist II, Protein Biology
Location: Bangalore, Karnataka, India
Job Id: R-01267698
Job Type: Full-time
Category: Research & Development
Remote: Fully Onsite
Work...
Biological Sciences Scientific Writer at Bristol Myers Squibb! Apply Now!
Biological Sciences Scientific Writer at Bristol Myers Squibb! Apply Now!
Scientific Writer II
Locations: Hyderabad - TS - IN
Time Type: Full time
Posted On: Posted Today
Job Requisition...
Clinical Data Specialist Job at IQVIA For Biological Sciences – Apply Now!
Clinical Data Specialist Vacancy at IQVIA For Biological Sciences - Apply Now!
Clin Data Spec
Bengaluru, India
Full time
R1439537
Job Description
Job Overview
Provide basic and some comprehensive data management...
Top 10 Biotech Research Areas With the Maximum Growth Potential!
Top 10 Biotech Research Areas with the Highest Growth Potential
“In the world of biotechnology, imagination is the only limit to what we can achieve.”
As...
Freshers MSc Life Science Opportunity at Neuberg – Apply Now
Freshers MSc Life Science Opportunity at Neuberg - Apply Now
CENTER FOR Neuberg GENOMIC DIAGNOSTICS MEDICINE
WE'RE HIRING: TECHNICAL SUPPORT EXECUTIVE (GENOMICS)
Location: Sindhu Bhavan, Ahmedabad
...
Biotecnika Times Newsletter 25.09.2024 – AcSIR PhD Admissions 2025, IGIB Bioinformatics Project Jobs, Syngene,...
AcSIR PhD Admission Notice For January 2025 Session - Official Notification
Applications are open for AcSIR PhD admissions for the January 2025 session. This is...
CSIR-IGIB Bioinformatics, Computational Biology Project Vacancy – Apply Online
IGIB Bioinformatics Project Vacancy - Computational Biology Apply Online
About CSIR-IGIB
CSIR-Institute of Genomics & Integrative Biology (IGIB) is a premier research institute under the Council...
IQVIA Life Sciences Proposal Writer Opportunity – Apply Online
IQVIA Life Sciences Proposal Writer Opportunity - Apply Online
Proposal Writer, SSR, PCS
Bengaluru, India
Full time
R1418767
Job Overview
Under general supervision, develop and prepare budgets and proposals for...
Principal Scientist Role at GSK For Life Sciences – Apply Now!
Principal Scientist Role at GSK For Life Sciences - Apply Now!
Principal Scientist, PV Operations - ICSR
Bengaluru, India
Medical and Clinical
404995
Job Description
Site Name: Bengaluru Luxor North...
Syngene Assay Biologist Role For MSc Life Sciences – Apply Now
Syngene Vacancies Life Science - Apply For Assay Biologist Role
Title: ASSAY BIOLOGIST
Date: 25 Sep 2024
Job Location: Bangalore
Pay Grade: 9-I
Years of Experience: 3 - 6...
LSRB-DRDO Funded Project Assistant Vacancy at Amity University – Apply Now
Project Assistant Vacancy at Amity University - Apply Now
Advertisement Date: 24.09.2024
Amity University Uttar Pradesh, Noida invites applications for
Amity Institute of Biotechnology
for Project Assistant
Name of...
AIIMS Delhi Scientist (Non-Medical) Job Vacancy Now Open For Life Sciences
AIIMS Delhi Scientist Non-Med Job For Life Sciences - Apply Now
Post Date: 24th Sep 2024
All India Institute of Medical Sciences
Ansari Nagar, New Delhi-29
Applications are...
Junior Research Fellow at IISER Mohali – Botany & Plant Biotechnology Walk-In
Junior Research Fellow at IISER Mohali - Botany & Plant Biotechnology Walk-In
Walk-in interview on October 08, 2024 to work as Junior Research Fellow (JRF)...